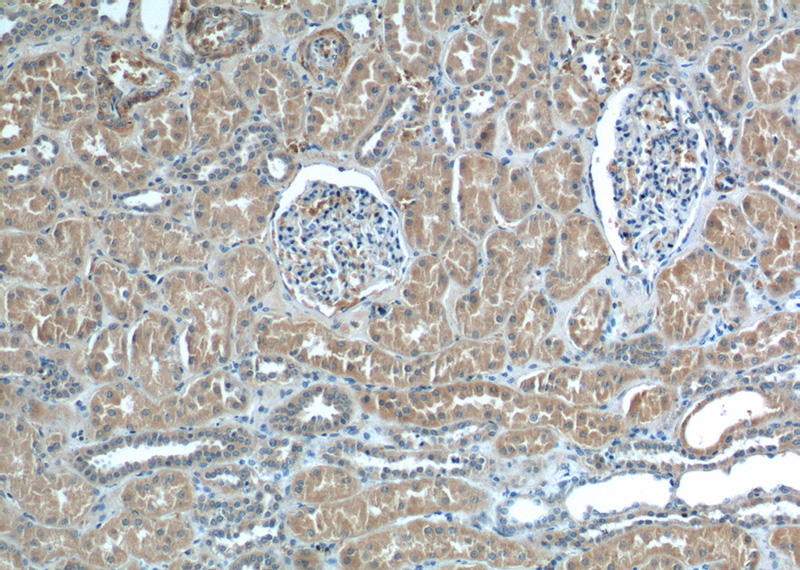
Immunohistochemistry of paraffin-embedded human kidney tissue slide using Catalog No:113730(PEX5 Antibody) at dilution of 1:200 (under 10x lens)
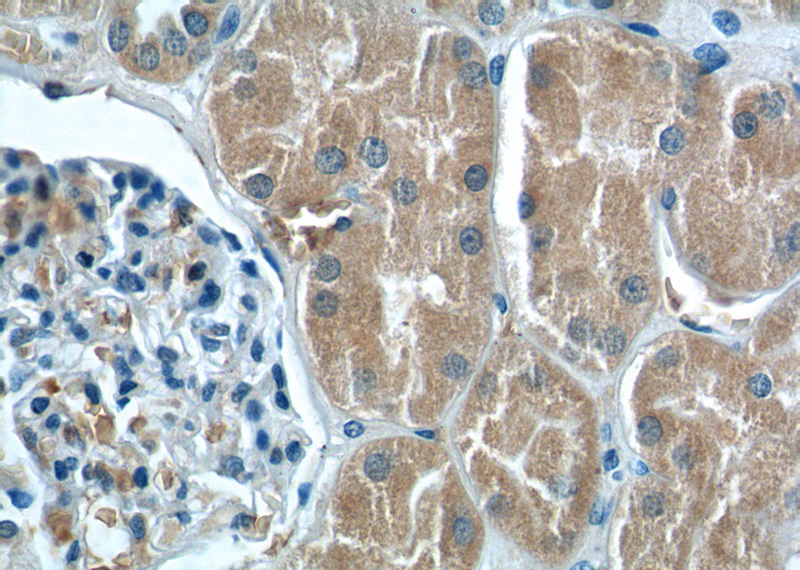
Immunohistochemistry of paraffin-embedded human kidney tissue slide using Catalog No:113730(PEX5 Antibody) at dilution of 1:200 (under 40x lens)

-
Product Name
PEX5 antibody
- Documents
-
Description
PEX5 Rabbit Polyclonal antibody. Positive IHC detected in human kidney tissue. Positive FC detected in HEK-293 cells. Positive WB detected in human brain tissue, human kidney tissue, L02 cells, mouse brain tissue, mouse kidney tissue. Positive IP detected in mouse kidney tissue. Observed molecular weight by Western-blot: 80 kDa
-
Tested applications
ELISA, WB, IP, IHC, FC
-
Species reactivity
Human,Mouse,Rat; other species not tested.
-
Alternative names
FLJ50634 antibody; FLJ50721 antibody; FLJ51948 antibody; Peroxin 5 antibody; Peroxisome receptor 1 antibody; PEX5 antibody; PTS1 BP antibody; PTS1 receptor antibody; PTS1R antibody; PXR1 antibody
- Immunogen
-
Isotype
Rabbit IgG
-
Preparation
This antibody was obtained by immunization of PEX5 recombinant protein (Accession Number: XM_047429267). Purification method: Antigen affinity purified.
-
Clonality
Polyclonal
-
Formulation
PBS with 0.1% sodium azide and 50% glycerol pH 7.3.
-
Storage instructions
Store at -20℃. DO NOT ALIQUOT
-
Applications
Recommended Dilution:
WB: 1:500-1:5000
IP: 1:200-1:2000
IHC: 1:20-1:200
-
Validations

human brain tissue were subjected to SDS PAGE followed by western blot with Catalog No:113730(PEX5 antibody) at dilution of 1:500

IP Result of anti-PEX5 (IP:Catalog No:113730, 4ug; Detection:Catalog No:113730 1:500) with mouse kidney tissue lysate 4000ug.
Immunohistochemistry of paraffin-embedded human kidney tissue slide using Catalog No:113730(PEX5 Antibody) at dilution of 1:200 (under 10x lens)
Immunohistochemistry of paraffin-embedded human kidney tissue slide using Catalog No:113730(PEX5 Antibody) at dilution of 1:200 (under 40x lens)

1X10^6 HEK-293 cells were stained with 0.2ug PEX5 antibody (Catalog No:113730, red) and control antibody (blue). Fixed with 4% PFA blocked with 3% BSA (30 min). Alexa Fluor 488-congugated AffiniPure Goat Anti-Rabbit IgG(H+L) with dilution 1:1500.
-
Background
The peroxisomal targeting signal type1 (PTS1) receptor, PEX5, is one member of peroxins (PEXs) which are proteins required for peroxisome assembly. PEX5 and PEX7 function as receptors that recognize PTS1- and PTS2- containing proteins, respectively, and PEX5 binds PTS1 through its C-terminal 40-kDa tetratricopeptide repeat domain. It is a predominantly cytoplasmic, partly peroxisomal protein that appears to shuttle between these compartments as it mediates the import of PTS1-containing proteins. PEX5 has been reported to interact with PEX10, PEX12, PEX13, and PEX14. Defects in PEX5 are a cause of Zellweger syndrome (ZWS), which is a lethal peroxisome biogenesis disorder. This antibody recognizes endogenous PEX5, which migrates with an apparent molecular mass of 80 kDa (PMID: 7790377).
-
References
- Zhang J, Kim J, Alexander A. A tuberous sclerosis complex signalling node at the peroxisome regulates mTORC1 and autophagy in response to ROS. Nature cell biology. 15(10):1186-96. 2013.
- Barøy T, Koster J, Strømme P. A novel type of rhizomelic chondrodysplasia punctata, RCDP5, is caused by loss of the PEX5 long isoform. Human molecular genetics. 24(20):5845-54. 2015.
- Zhang J, Tripathi DN, Jing J. ATM functions at the peroxisome to induce pexophagy in response to ROS. Nature cell biology. 17(10):1259-69. 2015.
Related Products / Services
Please note: All products are "FOR RESEARCH USE ONLY AND ARE NOT INTENDED FOR DIAGNOSTIC OR THERAPEUTIC USE"
